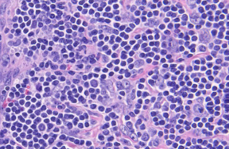

Applied AI and Bioinformatics Division
AI-Powered Precision
for Real-World Impact
We bridge the gap between cutting-edge research and clinical application to make diagnostics faster, more accurate, and more accessible.
Solutions
We collaborate with you to turn complex biomedical data into scientific breakthroughs, delivering the tools and technology you need to succeed.
Our data scientists sit at the intersection of computational expertise and clinical insight. With deep experience in large language models, machine learning, image analysis, and statistical modeling, our team transforms complex biomedical data into actionable tools for diagnostics, research, and operational decision-making.
We specialize in:
- Digital pathology and image analysis: Using advanced algorithms and artificial intelligence (AI) models, we develop solutions that support automated tissue classification, biomarker quantification, and diagnostic augmentation, including work on formalin-fixed paraffin-embedded (FFPE) and whole-slide images (WSIs).
- Predictive modeling: From disease progression forecasting to test utilization optimization, our predictive analytics help clients make informed decisions backed by data.
- Custom algorithm development: Whether it’s deep learning models for rare disease or rule-based engines for lab operations, we design and validate tailored tools to meet unique clinical needs.
- Data integration and interpretation: Our team excels at unifying structured and unstructured data—from genomics and lab results to electronic medical record (EMR) and imaging data—into coherent models that drive insight and impact.
- Translational research support: We partner with pharmaceutical and biotechnology clients to support biomarker discovery, companion diagnostic development, and clinical trial analytics.
What sets us apart is our ability to collaborate across scientific, engineering, and clinical teams, bridging the gap between innovative algorithms and real-world applications. Whether you’re exploring AI-driven diagnostics or seeking to accelerate research and development with intelligent data solutions, our data scientists bring the technical precision and biomedical context to help you succeed.
We build the technical infrastructure that powers some of the most ambitious innovations in clinical diagnostics.
As leaders in digital pathology and machine learning, our software engineering group can:
- Design and maintain production-grade, cloud-based tools and web applications to enable clinicians and researchers to visualize, analyze, and interact with large-scale WSIs and complex pathology datasets.
- Develop robust pipelines for ingesting, storing, and serving gigapixel pathology images. From high-throughput slide viewers to scalable annotation platforms, our systems are purpose-built to handle the size, sensitivity, and nuance of medical imaging data.
- Implement intuitive, performance interfaces that make it easy for users to interact with rich clinical data.
- Translate machine learning research into deployable tools. We write software to support model training and validation, build application programming interfaces (APIs) to serve inference results, and integrate these capabilities directly into lab workflows.
- Engineer custom interfaces to vendor-specific hardware (e.g., scanners, lab instruments, and digital imaging systems) to ensure seamless data exchange across the broader ecosystem.
Whether we’re architecting a distributed microservice system, solving complex visualization challenges, or deploying a deep learning model into a production environment, we help labs operate more efficiently and enable faster, more accurate diagnosis.
About Us
At the ARUP Applied AI and Bioinformatics Division, we work at the forefront of biomedical innovation, building tools and technologies that transform the way diagnostics, research, and patient care are delivered. Whether it’s developing advanced AI for digital pathology or creating scalable software to power the next generation of lab testing, we push the boundary of what’s possible. We build solutions that span disciplines from pathology image analysis to genomics, flow cytometry, infectious disease, and more.
We’re a multidisciplinary group of engineers, data scientists, medical experts, and innovators who believe the best solutions come from teams that are curious, collaborative, and mission driven.
We thrive in ambiguity, push technical boundaries, and operate with scientific rigor. And we do it to support patients, physicians, and researchers who rely on trusted answers.
Our Team
Leadership

Robert Ohgami, MD, PhD, FCAP
Vice President, ARUP Institute for Research and Innovation in Diagnostic and Precision Medicine™

David Ng, MD, FCAP
Senior Medical Director of Applied AI and Bioinformatics

Nick Spies, MD
Medical Director of Applied AI and Clinical Chemistry

Brendan O’Fallon, PhD
Director of Applied AI and Engineering

Mark Dewey, MS
Supervisor of IT Software Development

Ashley Hutchings, BS
Project Manager II
Data Scientists

Muir Morrison, PhD
Research Data Scientist III

Lauren Zuromski, MS
Research Data Scientist II

Jacob Durtschi, PhD
Research Data Scientist II

Mattia Medina Grespan, PhD
Research Data Scientist II

Paul English, BS
Research Data Scientist II

Alexandra Rangel, PhD
Research Data Scientist I
Engineers

Austin Wheeler, MS
IT Software Programmer IV

Chris Monson, BS
IT Software Programmer IV

Ray Linford, BS
IT Software Programmer III
Weston Prestwich, BS
IT Software Programmer III
Evelyn Goodman, BS
IT Software Programmer II
Portfolios and Publications
Castleman Disease Education Portal
We’re collaborating with Recordati Rare Diseases to advance the understanding, diagnosis, and treatment of idiopathic multicentric Castleman disease (iMCD), a rare and often misdiagnosed lymphoproliferative disorder. Through this partnership, we are delivering a comprehensive suite of educational resources, AI-powered diagnostic tools, and actionable research insights to support clinicians and researchers.
In close collaboration with leading medical experts in Castleman disease, our team has developed and is promoting a standardized diagnostic framework aimed at increasing accuracy and consistency across the medical community. Our data scientists have developed a state-of-the-art AI model that analyzes digitized histopathology slides to objectively grade iMCD severity, aiding pathologists in their clinical assessments.
To support knowledge sharing, our engineers created an interactive educational website that offers up-to-date information on Castleman disease, detailed tutorials on the grading process, and real-world case studies to enhance hands-on learning.
Pramana Hematopathology AI
Using the latest scanning technology from Pramana, we are developing AI tools to improve diagnostic accuracy and workflow efficiency through the digitization of complex tissue specimens and the development of novel machine learning algorithms. This partnership focuses on one of the most challenging domains in anatomic pathology—bone marrow biopsy interpretation—for which traditional diagnostic methods are limited by variability, complexity, and throughput constraints.
Pramana’s SpectralHT scanners, equipped with edge-based AI computing, are deployed to digitize hematopathology slides at scale with volumetric fidelity and real-time quality control. These scanners generate high-resolution images suitable for algorithmic interrogation, while simultaneously streamlining slide processing through autonomous imaging and in-line analysis.
Leveraging ARUP’s domain expertise in hematopathology and robust digital infrastructure, the Research and Innovation (R&I) team leads the design, annotation, and development of AI models that assist with diagnostic interpretation. This includes curating and labeling large-scale, real-world datasets using expert-reviewed clinical cases, training deep learning models to recognize morphological patterns, and optimizing them for on-device execution. By integrating model inference directly into the scanner workflow, the team is enabling near real-time decision support at the point of image acquisition.
This collaboration illustrates the practical convergence of clinical-grade AI and digital pathology systems. It exemplifies how domain-informed algorithm development, combined with scalable edge deployment, can enhance diagnostic precision, reduce inter-observer variability, and drive efficiency in routine and specialized pathology workflows. The initiative also serves as a foundation for future commercialization, with models developed for seamless integration into laboratory environments in alignment with evolving regulatory pathways.
Through this work, ARUP and Pramana are redefining diagnostic workflows in hematopathology and setting new standards for AI-enabled clinical diagnostics.
Jalapheno

Jalapheno helps medical directors and variant scientists analyze whole genomes and exomes rapidly. Modern genome sequencing can identify millions of sequence variants in an individual, but finding which ones are medically relevant is a complex and time-consuming task. A single genome can sometimes require hours of manual review and research to accurately characterize the variants. The Jalapheno algorithm makes this task easier by identifying which genes in the genome are most likely to be associated with the clinical findings for a patient. Using these results, scientists can focus their efforts on areas of the genome most likely to be associated with the patient’s individual condition. By filtering down the millions of variants to just a few, Jalapheno helps patients receive accurate results faster. The algorithm works by combing public databases and journal articles to find information about clinical disease symptoms, known as “phenotypes,” and genes known to be associated with them. Jalapheno then assembles millions of these data points into a large graph of gene-phenotype associations, structured in a way to make searches lightning fast. Today, Jalapheno is used in clinical genome and exome workflows at ARUP, helping patients get accurate results, faster.
Aide

Aide is a cloud-based annotation and collaboration platform designed to streamline the curation and analysis of WSIs for research and diagnostic development. Built specifically for the unique demands of digital pathology, Aide enables distributed teams of pathologists, scientists, and engineers to collaboratively annotate, tag, and manage large-scale WSI datasets with efficiency and precision.
Aide supports project-based workflows, allowing users to create and share collections of WSIs across teams. Within these projects, users can generate structured annotations, apply customizable metadata tags, and search across slides using tag-based and contextual filters. The platform’s web-based interface allows seamless access across institutions, making it ideal for multi-site collaboration and remote expert review.
By centralizing annotation efforts in a secure, cloud-native environment, Aide addresses a critical bottleneck in AI development pipelines: the creation of high-quality, expert-labeled training data. The system is designed to maintain annotation fidelity, facilitate inter-observer consensus, and ensure metadata consistency—all essential components for the reproducibility and scalability of machine learning workflows.
Aide’s modular architecture also supports downstream integration with AI model training, data versioning, and digital pathology viewers, making it a cornerstone in the broader ecosystem of ARUP’s digital pathology infrastructure. Whether supporting internal research projects or external collaborations, Aide is accelerating the development of clinically relevant AI tools by enabling efficiency and turning high-resolution insights into complex tissue-based datasets.
Careers
Who We Are
We believe that the best ideas emerge from diverse minds working together in a culture of curiosity, rigor, and collaboration. Our team includes engineers, data scientists, researchers, and medical professionals united by a shared drive to make a meaningful impact.
Who Are We Looking For?
We’re looking for problem-solvers, builders, and big-picture thinkers. People who are excited by ambiguity and driven to create clarity. People who thrive at the intersection of science, technology, and healthcare.
If you’re passionate about improving diagnostics, enabling precision medicine, and contributing to real-world solutions in healthcare—we want to hear from you.
Current openings:
DevOps Engineer III
In this role you will deliver innovative products and services at a rapid pace, enabling our development teams to serve our customers seamlessly across physical, digital and cloud platforms. You will be engineering a platform that provides services and frameworks to developers as a secure, scalable and highly available platform by using a variety of technologies such as AWS, Windows, Linux, SaltStack, MS SQL, MongoDB, RabbitMQ, Docker, Octopus. Own, automate and troubleshoot the Production Releases for a complex set of Biocomputing solutions.
Project Manager I -Technical
Responsible to facilitate projects including project definition and scope, deliverable, risk assessment, milestones, project tracking, and status reporting. The Project Manager provides project leadership, management, and oversight throughout the project but usually does not provide ongoing support of solutions post-deployment. Independently manages projects small to large in scope and complexity, and at any level of the organization. Responsible for leading, organizing, coordinating, monitoring and communicating Information Technology centric and/or complex enterprise projects or programs from initiation through delivery.
Collaborate With Us